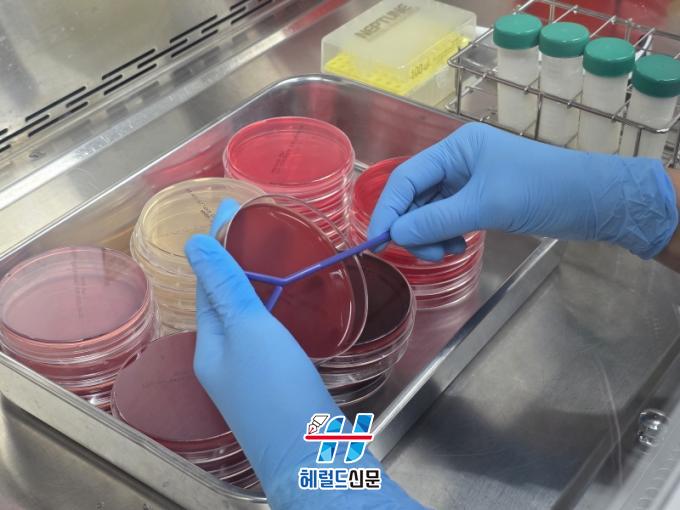

최신기사
- 제주특별자치도교육청, 장애학생 바리스타 직무체험 운영
- 서귀포시, ‘식품 안심업소’ 연중 모집
- 제주시, 제주수눌음지역자활센터 도서 나눔 기탁식 개최
- 김영록 예비후보, 광주전남 사회복지시설 종사자 처우 서울특별시 수준 맞춰 지원
- 제주시, 찾아가는 돌봄정책 현장 홍보 활동 전개
- 제주시교육지원청,‘기초학력 탄탄학교’ 업무담당자 협의회 개최
- 제주특별자치도교육청, 업무도움자료 ‘콕콕 짚어 보는 학교생활기록부’ 발간
- 강성휘 목포시장 예비후보, 민주당경선 TV토론서 정책‧실행력 동시 부각
- 강성휘 목포시장 예비후보, 더불어 민주당 경선 입장문 발표
- 서귀포시청소년수련관, 2026 청소년동아리연합회 발대식 성료
전라남도 동물위생시험소, 고품질 원유 생산 관리체계 강화
원유 검사·농가 지도 등 낙농가 생산성 향상 지원
노승언 기자
2025년 12월 05일(금) 17:53 가+가-
2025년 12월 05일(금) 17:53 가+가-
전라남도 동물위생시험소, 고품질 원유 생산 관리체계 강화
[헤럴드신문 = 노승언 기자] 전라남도동물위생시험소는 고품질 원유 생산을 위해 낙농가 원유 공영화 검사와 젖소 유방염 관리 체계를 강화한다고 밝혔다.
전남도동물위생시험소는 올 하반기 검사 속도와 정확성이 높은 체세포수 자동검사기와 유성분 분석기 등 최신 장비를 신규 도입했다. 이를 토대로 철저한 원유 공영화 검사를 수행하고 있다.
젖소 유방염은 세균·곰팡이 등 미생물의 유방 침입으로 발생하며, 원유 생산량 감소와 세균수·체세포수 증가로 품질을 떨어뜨린다. 농가 감염 확산, 도태율 증가, 치료비 부담 등 직·간접 피해도 크다.
최근에는 포도알균속, 황색포도알균, 대장균 등 대표적 원인균뿐만 아니라 환경성 연쇄알균·장알균 등 환경성 세균에 의한 발병도 늘어 낙농가 사양·위생 관리의 중요성이 높아지고 있다.
이에 따라 전남도동물위생시험소는 매주 생산 원유의 세균수·체세포수를 분석해 위생등급을 평가하고, 유방염 원인균 진단과 항생제 감수성 검사로 농가와 개체별 최적 치료제를 안내하고 있다. 축사 환경 개선, 소독 강화, 착유 위생관리 교육 등 예방 지도도 함께 펼치고 있다.
정지영 전남도동물위생시험소장은 “겨울철은 낮은 기온과 축사 환경 변화로 원유 위생과 품질에 세심한 신경을 써야 할 시기”라며 “신규 장비와 체계적 검사로 농가 피해를 최소화하고 안전한 우유 생산에 최선을 다하겠다”고 말했다.
최근 전남지역 220개 젖소 농가 원유는 세균수 1등급 98%, 체세포수 1등급 64%를 기록했다.
전남도동물위생시험소는 올 하반기 검사 속도와 정확성이 높은 체세포수 자동검사기와 유성분 분석기 등 최신 장비를 신규 도입했다. 이를 토대로 철저한 원유 공영화 검사를 수행하고 있다.
젖소 유방염은 세균·곰팡이 등 미생물의 유방 침입으로 발생하며, 원유 생산량 감소와 세균수·체세포수 증가로 품질을 떨어뜨린다. 농가 감염 확산, 도태율 증가, 치료비 부담 등 직·간접 피해도 크다.
최근에는 포도알균속, 황색포도알균, 대장균 등 대표적 원인균뿐만 아니라 환경성 연쇄알균·장알균 등 환경성 세균에 의한 발병도 늘어 낙농가 사양·위생 관리의 중요성이 높아지고 있다.
이에 따라 전남도동물위생시험소는 매주 생산 원유의 세균수·체세포수를 분석해 위생등급을 평가하고, 유방염 원인균 진단과 항생제 감수성 검사로 농가와 개체별 최적 치료제를 안내하고 있다. 축사 환경 개선, 소독 강화, 착유 위생관리 교육 등 예방 지도도 함께 펼치고 있다.
정지영 전남도동물위생시험소장은 “겨울철은 낮은 기온과 축사 환경 변화로 원유 위생과 품질에 세심한 신경을 써야 할 시기”라며 “신규 장비와 체계적 검사로 농가 피해를 최소화하고 안전한 우유 생산에 최선을 다하겠다”고 말했다.
최근 전남지역 220개 젖소 농가 원유는 세균수 1등급 98%, 체세포수 1등급 64%를 기록했다.
노승언 기자 기사 더보기
hrd299@naver.com
정치
사회
실시간 HOT 뉴스
- 1제주특별자치도, 전국 최초 1학생 1스포츠 4월…
- 2제주특별자치도, 78주년 4.3희생자 추념식 봉…
- 3제주특별자치도, 수출 역대 최고 실적 기여 유공…
- 4서귀포시, 힐링(UP!) 혼디모영 걸을락(樂) …
- 5서귀포시청소년수련관, 2026 청소년동아리연합회…
- 6서귀포시, 2026년 공직자 성인지.4대폭력 예…
- 7서귀포시, ‘식품 안심업소’ 연중 모집
- 8제주시, 어촌뉴딜300 사업 완료지 시설물 합동…
- 9제주시, 2026년 학생 승마지원 사업 참여자 …
- 10제주시, 제주수눌음지역자활센터 도서 나눔 기탁식…
가장 많이본 뉴스
Copyright © 2019 헤럴드신문. All Rights Reserverd.






